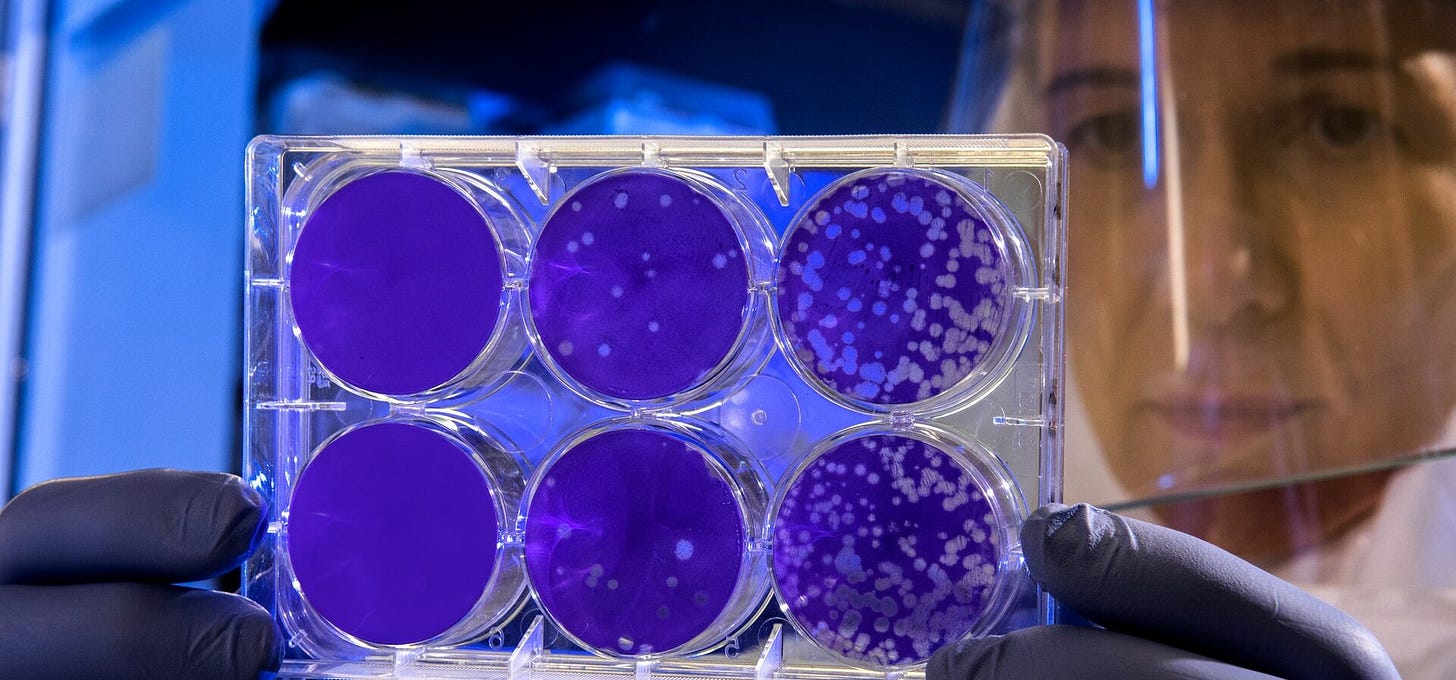

Virus Variants Easily Recognized by Immune Memory & Natural Antibodies
Unvaccinated / healthy people had nothing to do with the worsening of the pandemic.
– Virus variants (like Delta) are mainly driven by the vaccine-induced antibodies as they evolve around the artificially installed specific immunity while the natural cellular immunity is trying to detoxify, neutralize and dissolve the toxic vaccine ingredients and waste products thereby invoking viral symptoms and severe reactions due to a poisonous substance. Viruses also naturally mutate with or without vaccines. Unvaccinated / healthy people have nothing to do with the worsening of the pandemic. Don’t listen to those ignorant politicians and mainstream media who are trying to “blame the unvaccinated”. This was confirmed by competent scientists & virologists…
Keep reading with a 7-day free trial
Subscribe to CRONFACT - News to keep reading this post and get 7 days of free access to the full post archives.